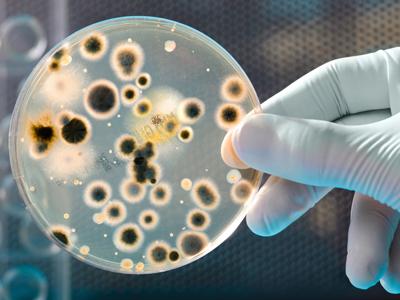

Вы здесь
Трихомоноз (или трихомониаз) - одно из самых распространенных инфекционных заболеваний мочеполовой системы, тяжело поддающееся лечению, богатое своими многочисленными осложнениями, в том числе это воспалительные заболевания мочеполовой сферы, сексуальные нарушения, бесплодие у мужчин и женщин. В запущенном течении болезни может потребоваться вызов уролога на дом СПб.
Возбудителем трихомоноза является трихомонада, простейший, животный организм, который гораздо крупнее целого ряда бактерий и вирусов, это - акула в миниатюре. При своем внедрении в половой тракт она не остается на поверхности слизистой оболочки, где обычно располагается большинство бактерий и вирусов, а, подобно кроту, пробуравливает поверхностные слои кожи и слизистой половых органов и внедряется туда поглубже, где в основном и располагается, выходя на поверхность для питания и других жизненных функций.
В начале 80-х годов нашего века было сделано открытие и с помощью электронной микроскопии доказано, что трихомонады в результате своей жизнедеятельности поглощают другие бактерии и вирусы, возбудителей инфекционных заболеваний, передающихся половым путем, таких как гонококки, хламидии, микоплазмы и другие, часть которых переваривается в них, а часть - живет внутри трихомонад, и при определенных условиях они могут выходить наружу. Все это сказано не для красного словца, а для того, чтобы понять, почему так трудно избавиться от трихомоноза и других инфекций половой системы, передающихся половым путем.
Хотя трихомоноз относится к инфекционным заболеваниям, передающимся половым путем, однако, по классификации, есть и трихомоноз девочек, т. е. внеполовой путь передачи и заражения через предметы домашнего обихода: унитаз, ванну, полотенце, простыни и т. д., т. е. человек может заразиться трихомонозом бытовым путем. Одна больная трихомонозом женщина, обратившаяся по поводу лечения, никак не могла понять, откуда у нее это заболевание, ведь они с мужем не изменяли друг другу. В ходе беседы она вспомнила, что некоторое время назад ей пришлось жить у подруги, пользоваться одним унитазом, ванной, иногда одним и тем же полотенцем. При разговоре с подругой стало известно, что она болела, но теперь совершенно здорова, так как применяла самолечение согласно рекламе по телевидению. Ей было предложено вновь пройти обследование, что она и сделала, в результате чего у нее вновь была найдена трихомонада, т. е. она послужила источником заражения своей подруги бытовым путем.
Инкубационный период при трихомонозе в среднем 14 дней. Течение заболевания незаметное, с периодами затишья и обострения. При этом может отмечаться зуд в половых органах, болезненность, дискомфорт при мочеиспускании, незначительные выделения и т. д., также характерен неприятный запах из половых органов. Вероятно, про супругов с воспалительными заболеваниями половых органов и именно болеющих тризомонозом великий Ги Де Мопасан сказал: "Супружеская жизнь - это терпеливое вынюхивание зловонных запахов в спальне друг друга".
Типичными осложнениями трихомоноза, ко всему прочему, являются хронический простатит у мужчин и эрозия шейки матки у женщин, т. к. для трихомонад очень благоприятной средой для жизнедеятельности являются предстательная железа у мужчин и шейка матки у женщин, куда они сразу стремятся с момента попадания в половые органы, т. е. с момента заражения, и обнаруживаются в шейке матки у женщин довольно быстро, а в предстательной железе у мужчин через 2-3 недели.
Есть мнение, что трихомоноз может вызвать доброкачественные и злокачественные опухоли мочеполовой системы женщин и мужчин (фибромиомы, аденомы, рак и т. д.).
Поэтому не верьте советам друзей и подруг, что трихомоноз вылечить легко за один или несколько приемов лекарств, не занимайтесь самолечением, а при любом дискомфорте со стороны мочеполовой системы принимайте своевременные и соответствующие меры - обследуйтесь и лечитесь у врача.
